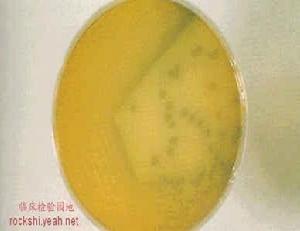
動物疫源菌

動物疫源菌
動物疫源菌這些病原體的特點
①宿主範圍很廣。②許多是職業病。
③可為研究人類傳染病提供良好的動物模型。
④人獸共患,既危害牲畜,又引起人類傳染病。
⑤常被霸權主義者用來作為生物戰劑。這些病原體包括細菌、病毒、立克次體、衣原體及鉤端螺旋體等。
動物疫源菌是指感染人類的病菌來自宿主動物,可通過直接接觸媒介動物,也可經污染物(土壤、污水和食物等)而傳播。動物疫源菌屬人畜共患疾病(zoonosis)的病原菌。
動物疫源菌自然疫源性疾病:在傳染源,以及在一定具體條件下,病原體向周圍傳播時所可能波及的範圍稱為疫源地,即可能發生新病例或新感染的範圍,它包括傳染源的停留場所和傳...
名稱 基本概念 影響自然疫源性疾病的因素 新發現傳染病與自然疫源的關係《中華人民共和國動物防疫法》,為加強對動物防疫活動的管理,預防、控制和撲滅動物疫病,促進養殖業發展,保護人體健康,維護公共衛生安全制定本法。由1997年...
簡介 1997年中華人民共和國動物防疫法 2007年中華人民共和國動物防疫法鼠疫耶氏菌(Y.pestis)俗稱鼠疫桿菌,是鼠疫的病原菌。 致病物質本菌為一種腸道致病菌,具有侵襲性及產毒素性。 本菌為動物源性細菌,致病物質為莢膜與內毒素。
一 布魯菌屬 二 耶爾森菌屬 三 芽胞桿菌屬 四 弗朗西絲菌屬 五 巴斯德菌屬第十條 第十五條 第二十條
簡介 管理辦法卵菌是一類真核生物,是多分枝的群體,包括許多植物病原菌,引起許多作物、花卉等發生災難性病害。卵菌具有獨特分類地位的群體,由於表現出絲狀等特性傳統上被劃分...
簡介 簡述 綜述 卵菌侵染敏感和抗病植物的早期《實驗動物科學》曾用名《北京實驗動物科學》、《北京實驗動物科學與管理》、《實驗動物科學與管理》等,1988後由北京實驗動物學學會、北京實驗動物研究中心及...
學科簡介 學科歷史 研究範圍 研究內容 研究意義《動物疫病流行病學》是2007年金盾出版社出版的圖書,作者是丁壯,楊松濤,喬紅偉。本書語言簡練,技術實用,可用作農業院校獸醫學專業本科生及碩士研究生教材...
圖書信息 內容簡介 圖書目錄《鼠疫動物流行病學》,是俞東征編著, 科學出版社出版的書籍。
內容簡介 圖書目錄 病原理論